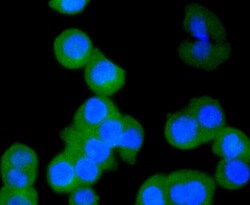

Antibody data
- Antibody Data
- Antigen structure
- References [0]
- Comments [0]
- Validations
- Immunocytochemistry [5]
- Immunohistochemistry [1]
- Flow cytometry [1]
Submit
Validation data
Reference
Comment
Report error
- Product number
- MA5-32319 - Provider product page

- Provider
- Invitrogen Antibodies
- Product name
- Cytokeratin 4 Recombinant Rabbit Monoclonal Antibody (SN74-03)
- Antibody type
- Monoclonal
- Antigen
- Recombinant full-length protein
- Description
- Recombinant rabbit monoclonal antibodies are produced using in vitro expression systems. The expression systems are developed by cloning in the specific antibody DNA sequences from immunoreactive rabbits. Then, individual clones are screened to select the best candidates for production. The advantages of using recombinant rabbit monoclonal antibodies include: better specificity and sensitivity, lot-to-lot consistency, animal origin-free formulations, and broader immunoreactivity to diverse targets due to larger rabbit immune repertoire.
- Reactivity
- Human
- Host
- Rabbit
- Isotype
- IgG
- Antibody clone number
- SN74-03
- Vial size
- 100 μL
- Concentration
- 1 mg/mL
- Storage
- Store at 4°C short term. For long term storage, store at -20°C, avoiding freeze/thaw cycles.
No comments: Submit comment
Supportive validation
- Submitted by
- Invitrogen Antibodies (provider)
- Main image

- Experimental details
- Immunocytochemical analysis of Cytokeratin 4 in A431 cells using a Cytokeratin 4 Monoclonal antibody (Product # MA5-32319) as seen in green. The nuclear counter stain is DAPI (blue). Cells were fixed in paraformaldehyde, permeabilised with 0.25% Triton X100/PBS.
- Submitted by
- Invitrogen Antibodies (provider)
- Main image

- Experimental details
- Immunocytochemical analysis of Cytokeratin 4 in Hela cells using a Cytokeratin 4 Monoclonal antibody (Product # MA5-32319) as seen in green. The nuclear counter stain is DAPI (blue). Cells were fixed in paraformaldehyde, permeabilised with 0.25% Triton X100/PBS.
- Submitted by
- Invitrogen Antibodies (provider)
- Main image
- Experimental details
- Immunocytochemical analysis of Cytokeratin 4 in SW480 cells using a Cytokeratin 4 Monoclonal antibody (Product # MA5-32319) as seen in green. The nuclear counter stain is DAPI (blue). Cells were fixed in paraformaldehyde, permeabilised with 0.25% Triton X100/PBS.
- Submitted by
- Invitrogen Antibodies (provider)
- Main image

- Experimental details
- Immunocytochemical analysis of Cytokeratin 4 in A431 cells using a Cytokeratin 4 Monoclonal antibody (Product # MA5-32319) as seen in green. The nuclear counter stain is DAPI (blue). Cells were fixed in paraformaldehyde, permeabilised with 0.25% Triton X100/PBS.
- Submitted by
- Invitrogen Antibodies (provider)
- Main image

- Experimental details
- Immunocytochemical analysis of Cytokeratin 4 in Hela cells using a Cytokeratin 4 Monoclonal antibody (Product # MA5-32319) as seen in green. The nuclear counter stain is DAPI (blue). Cells were fixed in paraformaldehyde, permeabilised with 0.25% Triton X100/PBS.
Supportive validation
- Submitted by
- Invitrogen Antibodies (provider)
- Main image

- Experimental details
- Immunohistochemical analysis of Cytokeratin 4 of paraffin-embedded Human tonsil tissue using a Cytokeratin-4 Monoclonal antibody (Product #MA5-32319). Counter stained with hematoxylin.
Supportive validation
- Submitted by
- Invitrogen Antibodies (provider)
- Main image

- Experimental details
- Flow Cytometric analysis of Cytokeratin 4 in A431 cells using a Cytokeratin 4 Monoclonal Antibody (Product # MA5-32319) at a dilution of 1:50, as seen in red compared with an unlabelled control (cells without incubation with primary antibody; black). Alexa Fluor 488-conjugated goat anti rabbit IgG was used as the secondary antibody.